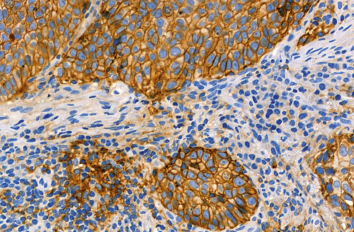

Journal Watch von unseren Experten
DOAK-Monotherapie bei Vorhofflimmern und stabiler koronarer Herzkrankheit risikoärmer als duale antithrombotische Therapie Frage: Ist die Inzidenz unerwünschter Ereignisse bei einer Monotherapie mit Edoxaban niedriger als bei einer dualen…